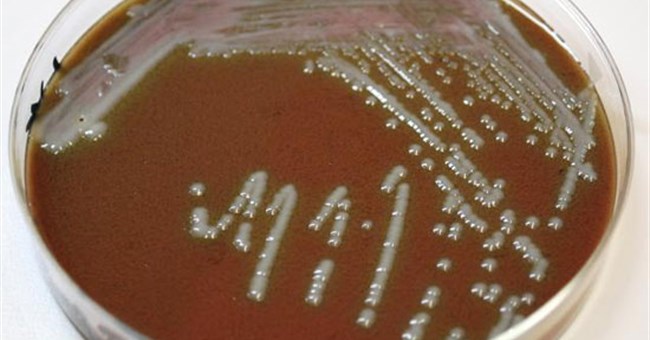
Vi khuẩn gây độc vượt qua hệ thống phòng thủ cơ thể như thế nào?

Phát hiện giun đất dài tới 2m

Loài giun đất khổng lồ Gippsland sống ở đông nam nước Úc được cho là loài giun lớn nhất thế giới.
Phản ứng nhiệt hạch là gì?

Phản ứng nhiệt hạch, hay phản ứng hợp hạch, phản ứng tổng hợp hạt nhân trong vật lý học, là quá trình 2 hạt nhân hợp lại với nhau để tạo nên một nhân mới nặng hơn.
Học theo Nga, NASA định bán vé du lịch lên ISS

NASA đang tính chuyện bán vé du lịch cho người dân có tiền lên trạm vũ trụ ISS, trước khi tiến tới việc xây dựng một trạm vũ trụ thương mại hóa vào năm 2025.
Phát hiện hình vẽ 12.000 năm tuổi có từ Kỷ băng hà

Các nhà khảo cổ học có một phát hiện đáng chú ý với những hình vẽ trong hang động ở miền đông nước Pháp có niên đại lên tới 12.000 năm tuổi, nằm ẩn dưới một lớp hình vẽ khác.
Tại sao có mặt trời lúc nửa đêm?

Bạn có phải là người yêu thích buổi sáng? Bạn có cảm thấy thời gian ban ngày không lúc nào đủ để bạn có thể hoàn thành tất cả các hoạt động mà bạn muốn không?
Phát hiện sinh vật kì lạ dưới biển sâu 1.300m

Một máy ảnh đặc biệt đã được các nhà khoa học đưa xuống độ sâu 1.300m dưới bề mặt đại dương và phát hiện ra một sinh vật kì lạ.
Thiếu máu nên ăn gì để cơ thể khỏe mạnh?

Ngoài các loại thịt có màu đỏ tươi, bí ngô, mía và nho là một trong các loại thực phẩm giúp bổ sung sắt tạo máu, đặc biệt cho những bà bầu.
Phát hiện mới: Vết thương của bạn lành nhanh hơn vào ban ngày so với ban đêm

Chúng ta thường tin rằng, giấc ngủ ban đêm có tác dụng làm lành và phục hồi vết thương nhanh hơn, bởi chức năng của giấc ngủ là giúp sạc lại năng lượng và chữa trị những vết thương trên cơ thể.
Ô nhiễm không khí gây tổn thọ hơn cả thuốc lá, chiến tranh và HIV/AIDS

Ô nhiễm không khí, mà nguyên nhân chủ yếu là đốt nhiên liệu hóa thạch, đang rút ngắn tuổi thọ loài người trên toàn cầu ở mức trung bình 1,8 năm/người, trở thành "sát thủ" hàng đầu hiện nay.
Mải tranh hươu, đàn chó săn rơi hàng loạt xuống vách đá

Các nhà hoạt động vì động vật chỉ trích một thợ săn thả đàn chó để săn hươu, khiến những con chó rơi hàng loạt xuống vực gần làng Herreruela ở tỉnh Caceres phía tây Tây Ban Nha.
Đèn chiếu sáng "ép" cây lớn nhanh, giảm nửa tiền điện

Các nhà khoa học Việt đã nghiên cứu, chế tạo loại bột huỳnh quang chuyên dùng trong nuôi cấy mô, giúp cây khỏe, không bị dị tật.
Ở Nga có loại cá hữu ích nhất thế giới

Cá và hải sản là nguồn chính cung cấp các axit béo không bão hòa đa thuộc hệ omega-3 như eicosapentaenoic và docosahexaenoic. S
Trái bóng chính thức tại AFF Cup 2018 đã được FIFA thử nghiệm như thế nào?

Công nghệ trong thể thao ngày càng quan trọng khi nó giúp một trận đấu diễn ra công bằng hơn với các cầu thủ.
 Chiếc gương 110 năm tuổi được cho từng thuộc sở hữu của thuyền trưởng tàu Titanic sẽ được bán đấu giá với mức giá khoảng 12.900 USD
Chiếc gương 110 năm tuổi được cho từng thuộc sở hữu của thuyền trưởng tàu Titanic sẽ được bán đấu giá với mức giá khoảng 12.900 USD Từ thế kỷ XX, thế giới của các siêu anh hùng cũng xuất hiện. Những cái tên như Hulk, T'Challa, Scarlet Witch... của Marvel thực sự hết sức hấp dẫn, khiến trẻ em đến người lớn đều đắm chìm.
Từ thế kỷ XX, thế giới của các siêu anh hùng cũng xuất hiện. Những cái tên như Hulk, T'Challa, Scarlet Witch... của Marvel thực sự hết sức hấp dẫn, khiến trẻ em đến người lớn đều đắm chìm. Thành phố tại bang Alaska đang trải qua thời kỳ bóng tối kéo dài gọi là "đêm vùng cực".
Thành phố tại bang Alaska đang trải qua thời kỳ bóng tối kéo dài gọi là "đêm vùng cực". Đoạn video được một người dân ở Houston, Texas (Mỹ) khiến người xem sởn gai ốc với “nhân vật chính” là một búi giun to ngoe nguẩy nhìn như bộ não người.
Đoạn video được một người dân ở Houston, Texas (Mỹ) khiến người xem sởn gai ốc với “nhân vật chính” là một búi giun to ngoe nguẩy nhìn như bộ não người. Cứ làm những điều này đi, xong đừng hỏi vì sao chân bạn cứ bốc mùi mãi không thôi.
Cứ làm những điều này đi, xong đừng hỏi vì sao chân bạn cứ bốc mùi mãi không thôi. Hầu hết các nghiên cứu cho thấy tập luyện dưới điều kiện mát mẻ hoặc lạnh giá mang lại nhiều lợi ích cho sức khoẻ của bạn.
Hầu hết các nghiên cứu cho thấy tập luyện dưới điều kiện mát mẻ hoặc lạnh giá mang lại nhiều lợi ích cho sức khoẻ của bạn. Sau khi chết, bạn muốn được hiến tặng cơ thể mình cho khoa học? Quả là một nghĩa cử cao quý, nhưng ngoài ra bạn vẫn còn rất nhiều sự lựa chọn.
Sau khi chết, bạn muốn được hiến tặng cơ thể mình cho khoa học? Quả là một nghĩa cử cao quý, nhưng ngoài ra bạn vẫn còn rất nhiều sự lựa chọn. Loài giun đất khổng lồ Gippsland sống ở đông nam nước Úc được cho là loài giun lớn nhất thế giới.
Loài giun đất khổng lồ Gippsland sống ở đông nam nước Úc được cho là loài giun lớn nhất thế giới. Phản ứng nhiệt hạch, hay phản ứng hợp hạch, phản ứng tổng hợp hạt nhân trong vật lý học, là quá trình 2 hạt nhân hợp lại với nhau để tạo nên một nhân mới nặng hơn.
Phản ứng nhiệt hạch, hay phản ứng hợp hạch, phản ứng tổng hợp hạt nhân trong vật lý học, là quá trình 2 hạt nhân hợp lại với nhau để tạo nên một nhân mới nặng hơn. NASA đang tính chuyện bán vé du lịch cho người dân có tiền lên trạm vũ trụ ISS, trước khi tiến tới việc xây dựng một trạm vũ trụ thương mại hóa vào năm 2025.
NASA đang tính chuyện bán vé du lịch cho người dân có tiền lên trạm vũ trụ ISS, trước khi tiến tới việc xây dựng một trạm vũ trụ thương mại hóa vào năm 2025. Các nhà khảo cổ học có một phát hiện đáng chú ý với những hình vẽ trong hang động ở miền đông nước Pháp có niên đại lên tới 12.000 năm tuổi, nằm ẩn dưới một lớp hình vẽ khác.
Các nhà khảo cổ học có một phát hiện đáng chú ý với những hình vẽ trong hang động ở miền đông nước Pháp có niên đại lên tới 12.000 năm tuổi, nằm ẩn dưới một lớp hình vẽ khác. Bạn có phải là người yêu thích buổi sáng? Bạn có cảm thấy thời gian ban ngày không lúc nào đủ để bạn có thể hoàn thành tất cả các hoạt động mà bạn muốn không?
Bạn có phải là người yêu thích buổi sáng? Bạn có cảm thấy thời gian ban ngày không lúc nào đủ để bạn có thể hoàn thành tất cả các hoạt động mà bạn muốn không? Một máy ảnh đặc biệt đã được các nhà khoa học đưa xuống độ sâu 1.300m dưới bề mặt đại dương và phát hiện ra một sinh vật kì lạ.
Một máy ảnh đặc biệt đã được các nhà khoa học đưa xuống độ sâu 1.300m dưới bề mặt đại dương và phát hiện ra một sinh vật kì lạ. Ngoài các loại thịt có màu đỏ tươi, bí ngô, mía và nho là một trong các loại thực phẩm giúp bổ sung sắt tạo máu, đặc biệt cho những bà bầu.
Ngoài các loại thịt có màu đỏ tươi, bí ngô, mía và nho là một trong các loại thực phẩm giúp bổ sung sắt tạo máu, đặc biệt cho những bà bầu. Chúng ta thường tin rằng, giấc ngủ ban đêm có tác dụng làm lành và phục hồi vết thương nhanh hơn, bởi chức năng của giấc ngủ là giúp sạc lại năng lượng và chữa trị những vết thương trên cơ thể.
Chúng ta thường tin rằng, giấc ngủ ban đêm có tác dụng làm lành và phục hồi vết thương nhanh hơn, bởi chức năng của giấc ngủ là giúp sạc lại năng lượng và chữa trị những vết thương trên cơ thể. Ô nhiễm không khí, mà nguyên nhân chủ yếu là đốt nhiên liệu hóa thạch, đang rút ngắn tuổi thọ loài người trên toàn cầu ở mức trung bình 1,8 năm/người, trở thành "sát thủ" hàng đầu hiện nay.
Ô nhiễm không khí, mà nguyên nhân chủ yếu là đốt nhiên liệu hóa thạch, đang rút ngắn tuổi thọ loài người trên toàn cầu ở mức trung bình 1,8 năm/người, trở thành "sát thủ" hàng đầu hiện nay. Các nhà hoạt động vì động vật chỉ trích một thợ săn thả đàn chó để săn hươu, khiến những con chó rơi hàng loạt xuống vực gần làng Herreruela ở tỉnh Caceres phía tây Tây Ban Nha.
Các nhà hoạt động vì động vật chỉ trích một thợ săn thả đàn chó để săn hươu, khiến những con chó rơi hàng loạt xuống vực gần làng Herreruela ở tỉnh Caceres phía tây Tây Ban Nha. Các nhà khoa học Việt đã nghiên cứu, chế tạo loại bột huỳnh quang chuyên dùng trong nuôi cấy mô, giúp cây khỏe, không bị dị tật.
Các nhà khoa học Việt đã nghiên cứu, chế tạo loại bột huỳnh quang chuyên dùng trong nuôi cấy mô, giúp cây khỏe, không bị dị tật. Cá và hải sản là nguồn chính cung cấp các axit béo không bão hòa đa thuộc hệ omega-3 như eicosapentaenoic và docosahexaenoic. S
Cá và hải sản là nguồn chính cung cấp các axit béo không bão hòa đa thuộc hệ omega-3 như eicosapentaenoic và docosahexaenoic. S Công nghệ trong thể thao ngày càng quan trọng khi nó giúp một trận đấu diễn ra công bằng hơn với các cầu thủ.
Công nghệ trong thể thao ngày càng quan trọng khi nó giúp một trận đấu diễn ra công bằng hơn với các cầu thủ.